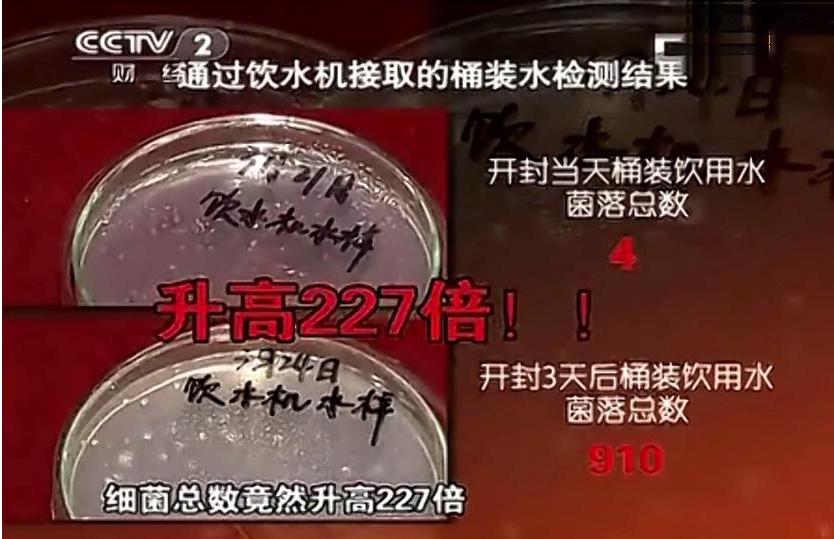
桶装水与净水器安全对比,桶装水和净水器哪个好知乎

饮水方式逐渐在发生改变,过去是烧开水,因为不方便,所以桶装水出现,解决饮水方便的问题。在许多家庭烧开水还算是方便,但在室外如商务办公室、图书馆、医院等,公共领域中,烧开水是不可能的,桶装水成为必选的方式。随着净水器的出现,饮水方式又多出一种选择,那么桶装水和净水器哪个更好?通过了解事实真相之后,才知道不少人被忽悠了!

桶装水和净水器哪个更好?
桶装水,通过桶装消毒处理后的纯净水,直饮或者饮水机加热使用,在许多家庭和商务公共领域中都有桶装水的存在,因为家庭便宜,饮水方便,很快速进入市场中,获得大众的喜爱和认可!

随着社会进步,自来水二次污染的出现,要解决家庭饮水和用水两重需要,净水器经过升级,可以满足家庭用水和饮水需要,在商用领域也获得大众的喜爱,许多家庭开始选择净水器,净水器开始替代桶装水。

同样是饮水需要,桶装水和净水器哪个更好呢?可能许多家庭使用而言,桶装水更好一些,价格便宜,净水器价格贵,还不知道效果好不好。那么我们来综合对比,了解真相,不少弄错了,被忽悠了!
桶装水的优势:
第一,价格便宜,一桶水价格10-20元不等。相对于净水器几千元的价位,很明显桶装水的价格便宜许多,所以一些家庭会选择桶装水的原因!
第二,桶装水不用可以退,搬家方便,不占地方!桶装水都是预约送水上面,所以不用了,是可以退订的!对于租住用户而言,桶装水更方便!
桶装水的缺点:
第一,更换桶装水比较费力,更换不方便。有时如果忘记预定更换桶装水,可能会出现没有水喝的情况。

第二,桶装水如果三天不用完,里面滋生的细菌会超标,时间越久细菌数量更多!
第三,桶装水的饮水机内部长期不清晰,里面最容易藏污纳垢,影响饮用水质!
净水器的优势:
第一,净水器直接连接自来水,快速过滤,饮水非常方便和快速!没有桶装水那么费力更换!

第二,净水器可以解决厨房洗菜做饭,还能满足家庭饮水的需要,一举两得!
净水器的缺点:
第一,净水器的价格偏高,滤芯成本也不低。
第二,净水器的滤芯需要定期更换,否则会二次污染自来水!
综合对比,净水器的优势好像没有桶装水好,尤其是价格方便,不占据优势,然而我们用水是一个长期的过程,不是短期来对比。那么长期而言来对比!
净水器的综合成本并不比桶装水高 。桶装水一桶水价格定在15元,一周两桶,一年的费用1440元,5年的费用7200。净水器的选择一台2000元的产品,每年的滤芯成本定在800,那么五年的费用成本是6000元!所以从长期用水而已,净水器并不比桶装水高,可能还会低于桶装水!

净水器的类型多样,满足不同的需要,适用范围更多 !如果你了解净水器的类型,针对不同的用水需要选择不同的类型,桶装水很单一,只是解决饮水需要。净水器的类型有前置净水器、超滤机、管线机、反渗透净水器、软水机、中央净水器等。超滤净水器满足厨房洗菜做饭,反渗透净水机适合饮水需要,软水机应对自来水水质偏硬的情况。中央净水器适合全屋净水需要等。净水器能解决自来水二次污染的情况,方便家庭饮水。相对而言,净水器的作用要多样化,更适合当前家庭用水需要!

在公共和商务领域,净水器适合人群更多饮用!在流动人比较多,饮水量大的情况下,净水器更具优势,能同时满足更多人饮水,而桶装水都是标准通量,面对人少多的情况下,要不预备不少桶装水替换,不方便!因此如今在许多公共领域,净水器的安装和使用已经开始替代了桶装水!

在不少人眼中,桶装水更好更划算,实际上在使用的过程中,就会发现净水器更具备优势,不仅它加热速度快,方便饮水,还能同时过滤自来水中的杂质,提升水质,解决某些地区水质比较差的情况!